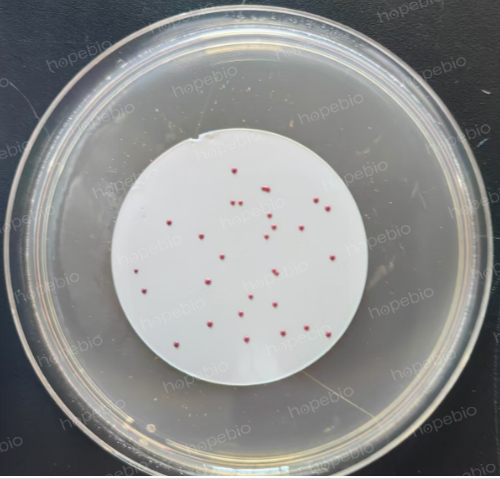
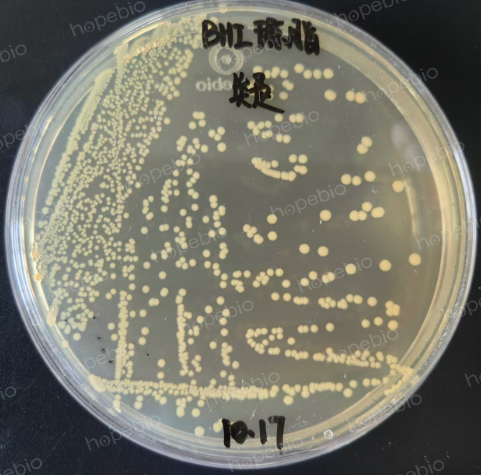

海博微信公众号
海博微信公众号
 海博天猫旗舰店
海博天猫旗舰店


 海博微信公众号
海博微信公众号
 海博天猫旗舰店
海博天猫旗舰店




一、简介
粪链球菌又叫粪肠球菌,是一种革兰染色阳性球菌。粪肠球菌是人体肠道内的正常菌群,人的大便中含有大量的粪肠球菌,每克粪便中大约有107个粪肠球菌。粪肠球菌通常不感染人,但在人应用抑制免疫力药物导致人体免疫力下降等情况下,会导致粪肠球菌感染。粪链球菌检验是饮用天然矿泉水检验标准的必检项目。参考标准为《GB 8538-2022 食品安全国家标准 饮用天然矿泉水检验方法》。粪链球菌的检验程序如下(图1):

图1 粪链球菌的检验程序
二、试验操作
1、水样过滤
用无菌镊子夹取无菌滤膜边缘部分,贴放在已灭菌的滤头上,固定好滤器,将250mL水样或稀释后的水样,通过孔径0.45μm的滤膜过滤(如图2)。

图2 水样过滤操作步骤
2、培养
将过滤后的滤膜贴在KF链球菌琼脂培养基平板上,滤膜截留细菌面向上,平铺并避免在滤膜和培养基之间夹留着气泡(如图3)。将平板倒置,36℃±1℃培养48h±2h。

图3 滤膜贴到培养基上培养前的状态
3、结果观察与计数
粪链球菌典型菌落在滤膜上呈现大小不等的红色或粉红色(如图4),计数可疑菌落。
图4 滤膜上的菌体培养后的状态
4、确证试验
a、从滤膜上按比例挑取10个不同形态的可疑菌落(不足10个则全挑),接种到脑心浸液琼脂培养基平板上,36℃±1℃培养24h~48h(如图5)。
图5 可疑菌株纯化后的状态
b、用接种环从脑心浸液琼脂培养基平板上挑取培养物进行革兰氏染色,镜检观察,可疑菌应为革兰氏阳性球菌(如图6)。

图6 革兰氏阳性球菌显微照片
c、用接种环从脑心浸液琼脂培养基平板上挑取培养物到一片清洁的载玻片上,滴加2滴~3滴新鲜配制的3%过氧化氢到载玻片的涂抹菌处。
如果30s内有气泡发生,则过氧化氢酶反应为阳性(如图7左),则该菌不属于粪链球菌,确证试验到此即可停止;如果30s内没有气泡发生(如图7右),则显示过氧化氢酶反应为阴性,则该菌可视为粪链球菌可疑菌,需继续后面的确证过程。

图7 过氧化氢酶阳性和阴性结果
d、用接种环从脑心浸液琼脂培养基平板上挑取单菌落到脑心浸液液态培养基内,45℃±1℃ 培养48h±2h(如图8)。

图8 脑心浸液肉汤中质控菌和可疑菌的生长情况
(从左到右:粪肠球菌,阳性菌,阴性菌,无菌对照)
同时挑取单菌落到胆汁液态培养基中,36℃±1℃ 培养3d(如图9)。

e、若可疑菌落为革兰氏阳性球菌,过氧化氢酶反应阴性,且分别接种至两种培养基中,培养后使两种培养基均变浑浊,则确证为粪链球菌(图10)。

图10 确证为粪链球菌的试验结果
三、结果与报告
粪链球菌菌落数按下面的公式计算:

式中:T———每250 mL水中粪链球菌的菌落数;
A———某一稀释度可疑菌落的总数;
B———某一稀释度确证为阳性的菌落数;
C———某一稀释度用于确证性试验的菌落数;
d———稀释因子。
四、质量控制
实验室应根据需要设置阳性对照、阴性对照和空白对照,定期对检验过程进行质量控制。宜选用粪肠球菌标准菌株[CMCC(B) 32482或等效标准菌株]作为阳性对照菌株,以大肠埃希氏菌标准菌株[CMCC(B) 43201或等效标准菌株]作为阴性对照菌株。
五、产品展示
本检验过程中用到的培养基产品信息列举如下,以期能给广大检验人员提供帮助。
|
序号 |
货号 |
名称 |
规格 |
用途 |
图片 |
链接 |
|
1 |
10只/袋*10/箱 |
用于水样的无菌采集(圆底立式) |
||||
|
2 |
10只/袋*15/箱 |
用于水样的无菌采集 |
||||
|
3 |
100 g |
用于粪链球菌的选择性分离培养及计数(GB8538-2022) |
||||
|
4 |
250 g |
营养丰富,用于培养各种细菌(GB8538-2022标准) |
||||
|
5 |
250 g |
营养丰富,用于培养各种细菌 |
||||
|
6 |
100 g |
用于粪链球菌的胆汁耐受试验(GB8538-2022标准) |
||||
|
7 |
5 ml*8 |
用于细菌的革兰氏染色试验 |
||||
|
8 |
20支 |
用于过氧化氢酶试验 |
注:本文属海博生物原创,未经允许不得转载。
| 相关文章: | ||



